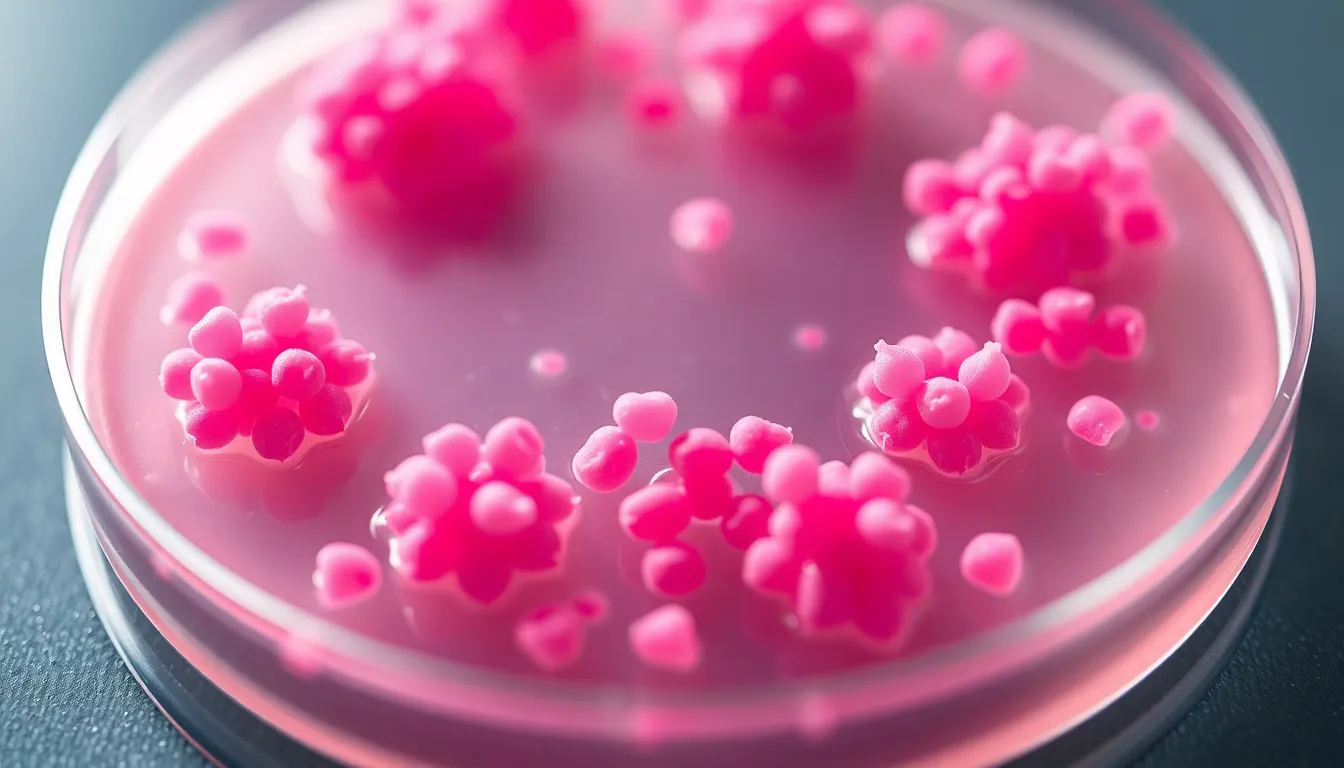

Related Images

Intricate Crystal Structure Under Spotlight

Microscopic View of Soil Microbes

Vibrant Microscopic Organism Under Warm Light

Artistic Arrangement of Microscope Samples

Close-Up of Microscopic Cell Structure

Macro View of Vibrant Specimen

Specimen Among Nature's Elements

Dramatic Specimen Illumination

Vibrant Specimen on Glass Slide

Intricate Cellular Structures Under Microscope

Human Cells Under Warm Light Microscope

Micro-Fossil Detail Under Microscope